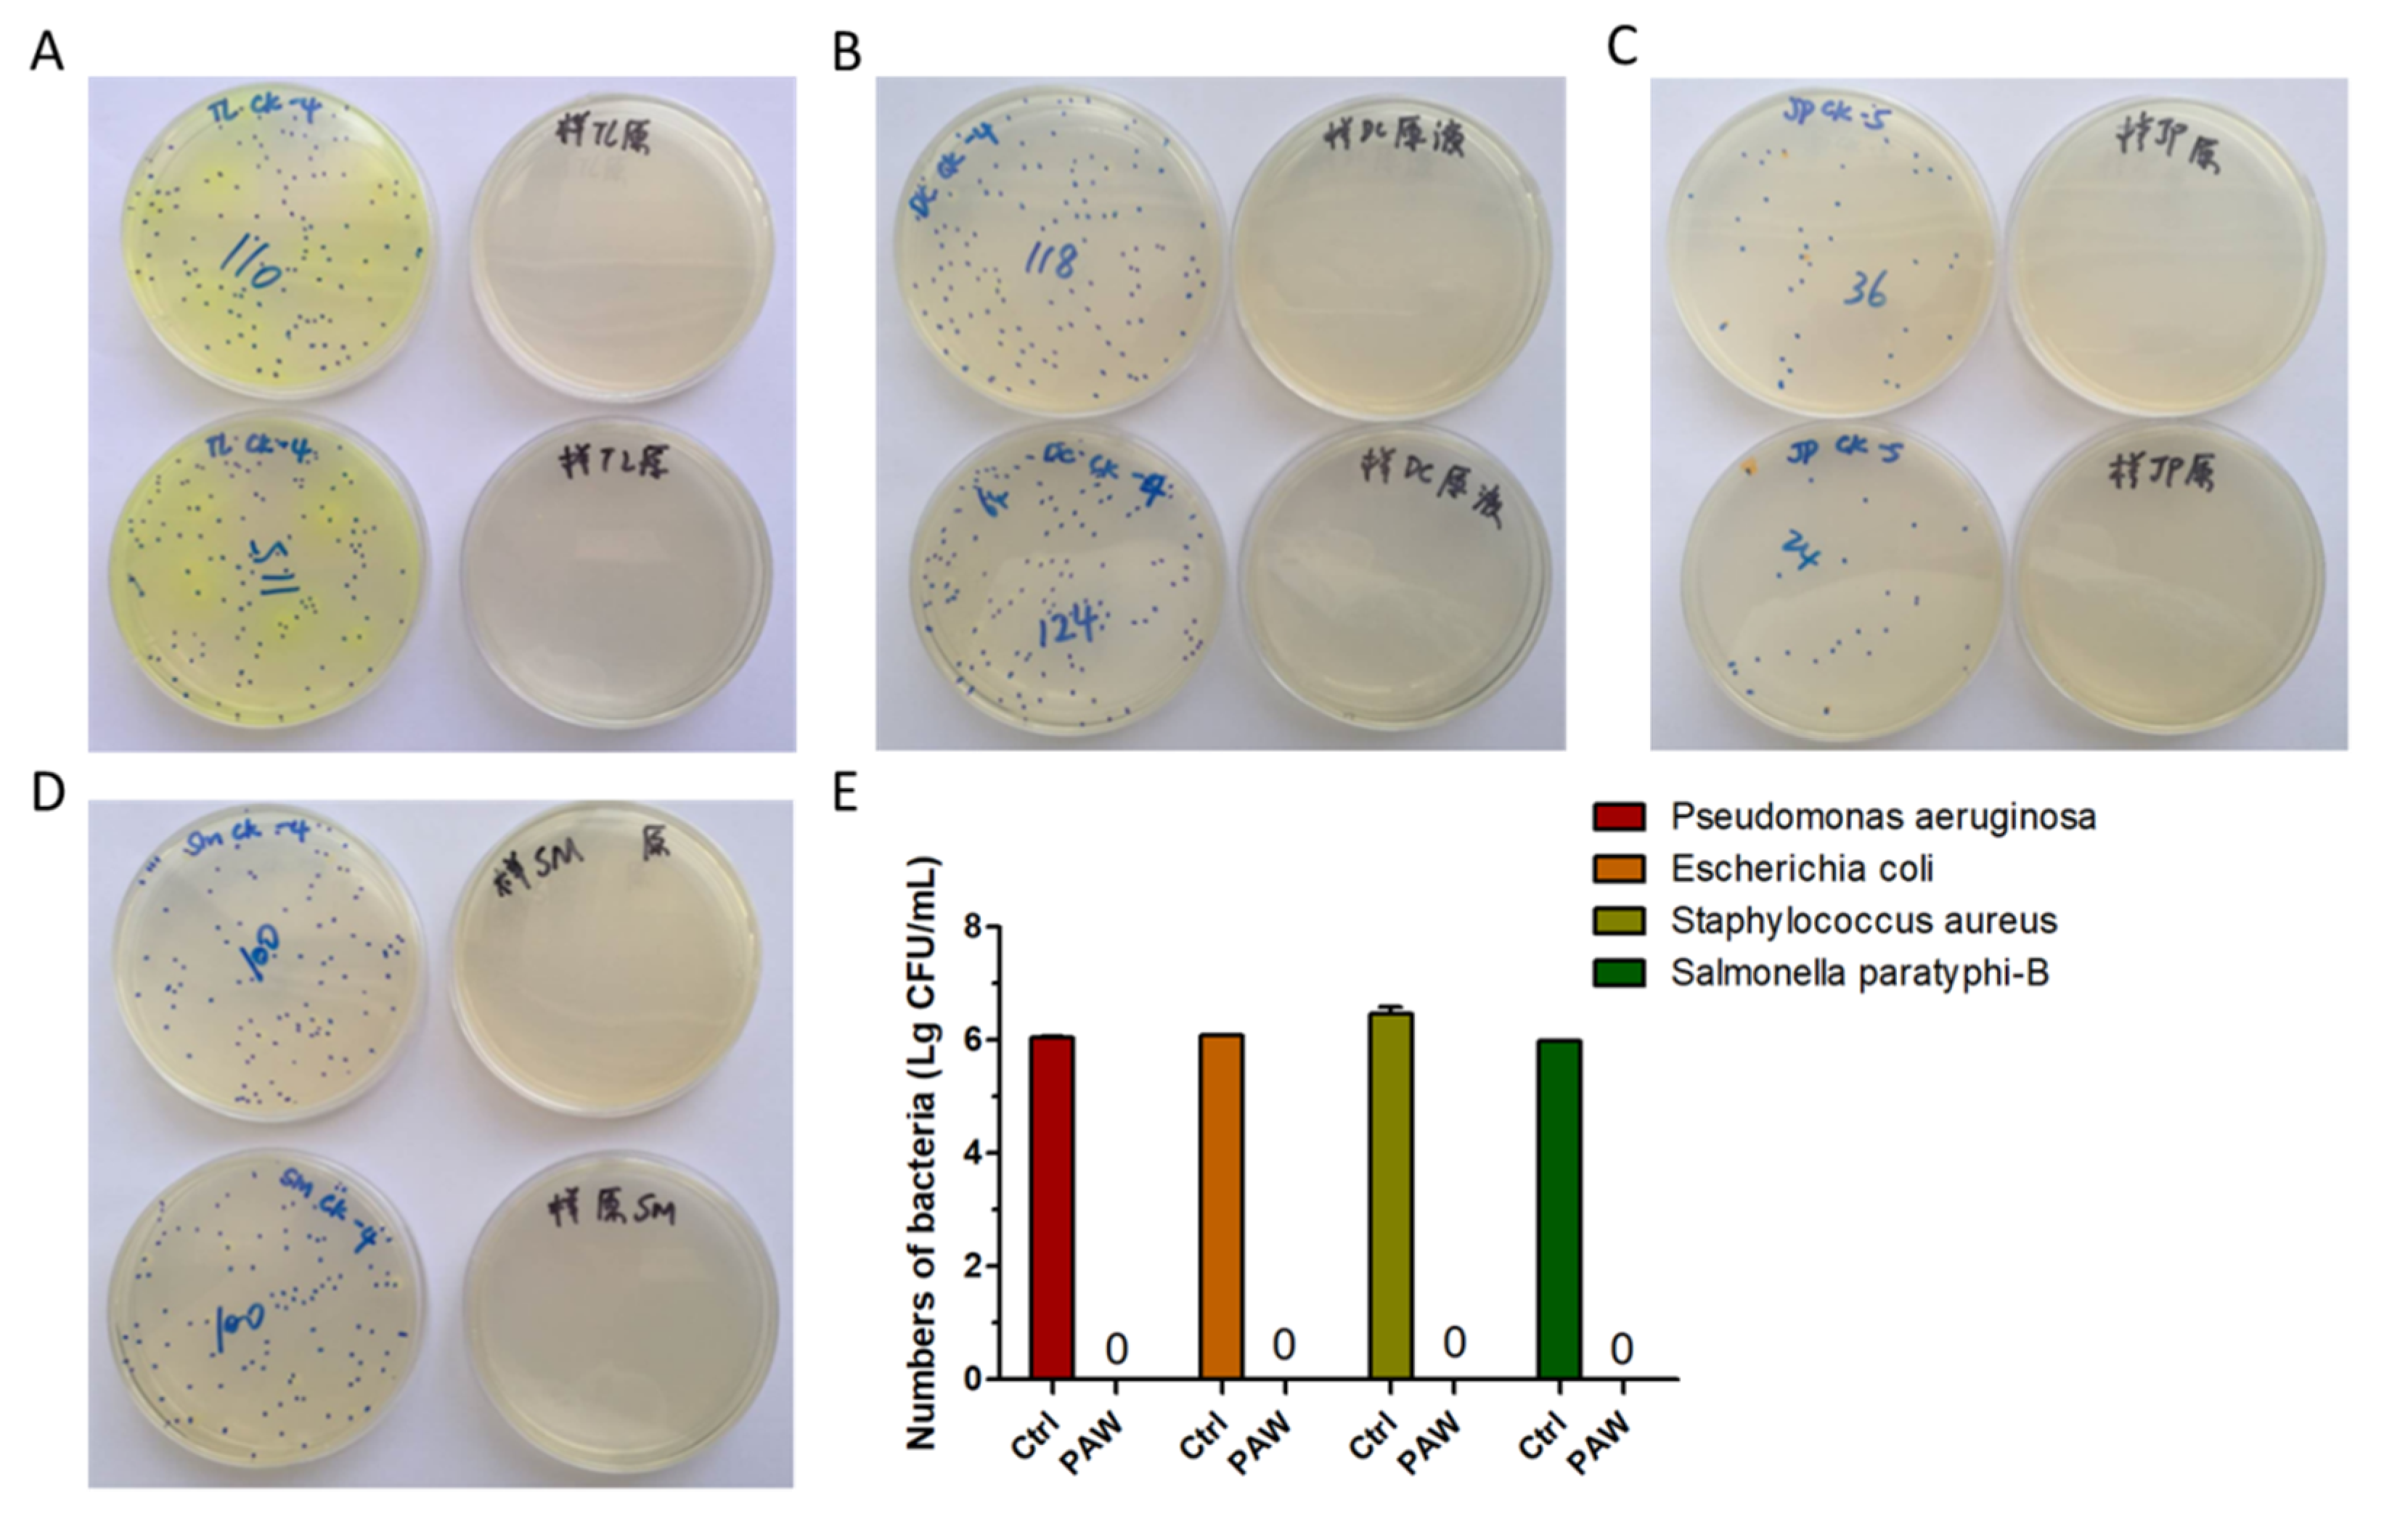
Microorganisms 08 01091 g003

Effects of Plasma-Activated Water on Skin Wound Healing in Mice
Abstract
1. Introduction
2. Materials and Methods
2.1. Animals and Wound Creation
2.2. Device Introduction and Wound Treatment
2.3. Wound Healing Analysis
2.4. Histological Analysis of Wound Skin
2.5. Inactivation of Bacteria by PAW
2.6. Analysis of Bacterial Inactivation in Wounds by DNA Sequencing
2.7. Analysis of Biological Safety of PAW
2.8. Statistical Analysis
3. Results and Discussion
3.1. Inactivation of Several Kinds of Bacteria That Commonly Infect Wounds
3.2. Skin Wounds Healing in Mice
3.3. Analysis of In Vivo Bacterial Inactivation by DNA Sequencing
3.4. Analysis of Biological Safety
4. Conclusions
Author Contributions
Funding
Conflicts of Interest
References
- Geoffrey, C.G.; Sabine, W.; Yann, B.; Michael, T.L. Wound repair and regeneration. Nature 2008, 453, 314–321. [Google Scholar]
- Lee, M.-J.; Lee, D.J.; Jung, H.-S. Wound healing mechanism in Mongolian gerbil skin. Histochem. Cell Biol. 2018, 151, 229–238. [Google Scholar] [CrossRef] [PubMed]
- Franks, P.J.; Barker, J.; Collier, M.; Gethin, G.; Haesler, E.; Jawien, A.; Laeuchli, S.; Mosti, G.; Probst, S.; Weller, C. Management of Patients With Venous Leg Ulcers: Challenges and Current Best Practice. J. Wound Care 2016, 25, S1–S67. [Google Scholar] [CrossRef] [PubMed]
- Hernandez, R. The use of systemic antibiotics in the treatment of chronic wounds. Dermatol. Ther. 2010, 19, 326–337. [Google Scholar] [CrossRef]
- Shao, T.; Zhang, C.; Wang, R.X.; Yan, P.; Ren, C.Y. Atmospheric-pressure Pulsed Gas Discharge and Pulsed Plasma Application. High Volt. Eng. 2016, 42, 685–705. [Google Scholar]
- Walsh, J.L.; Shi, J.J.; Kong, M.G. Contrasting characteristics of pulsed and sinusoidal cold atmospheric plasma jets. Appl. Phys. Lett. 2006, 88, 171501.1–171501.3. [Google Scholar] [CrossRef]
- Fridman, G.; Friedman, G.; Gutsol, A.; Shekhter, A.B.; Vasilets, V.N.; Fridman, A. Applied Plasma Medicine. Plasma Process. Polym. 2008, 5, 503–533. [Google Scholar] [CrossRef]
- Kong, M.G.; Kroesen, G.; Morfill, G.; Nosenko, T.; Shimizu, T.; van Dijk, J.; Zimmermann, J.L. Plasma medicine: An introductory review. New J. Phys. 2009, 11, 115012. [Google Scholar] [CrossRef]
- Nayansi, J.; Jun, R.J.; Ha, C.E.; Kumar, K.N. Generation and Role of Reactive Oxygen and Nitrogen Species Induced by Plasma, Lasers, Chemical Agents, and Other Systems in Dentistry. Oxidative Med. Cell. Longev. 2017, 2017, 7542540. [Google Scholar]
- Chen, Z.; Liu, D.; Xu, H.; Xia, W.; Liu, Z.; Xu, D.; Rong, M.; Kong, M.G. Decoupling analysis of the production mechanism of aqueous reactive species induced by a helium plasma jet. Plasma Sources Sci. Technol. 2019, 28, 025001. [Google Scholar] [CrossRef]
- He, T.; Liu, D.; Liu, Z.; Liu, Z.; Li, Q.; Rong, M.; Kong, M.G. The mechanism of plasma-assisted penetration of NO2- in model tissues. Appl. Phys. Lett. 2017, 111, 203702. [Google Scholar] [CrossRef]
- Liu, D.X.; Liu, Z.C.; Chen, C.; Yang, A.J.; Li, D.; Rong, M.Z.; Chen, H.L.; Kong, M.G. Aqueous reactive species induced by a surface air discharge: Heterogeneous mass transfer and liquid chemistry pathways. Sci. Rep. 2016, 6, 23737. [Google Scholar] [CrossRef] [PubMed]
- Pavlovich, M.J.; Chang, H.W.; Sakiyama, Y.; Clark, D.S.; Graves, D.B. Ozone correlates with antibacterial effects from indirect air dielectric barrier discharge treatment of water. J. Phys. D Appl. Phys. 2013, 46, 145202. [Google Scholar] [CrossRef]
- Reuter, S.; Winter, J.; Iseni, S.; Schmidt-Bleker, A.; Dunnbier, M.; Masur, K.; Wende, K.; Weltmann, K.D. The Influence of Feed Gas Humidity Versus Ambient Humidity on Atmospheric Pressure Plasma Jet-Effluent Chemistry and Skin Cell Viability. IEEE Trans. Plasma Sci. 2015, 43, 3185–3192. [Google Scholar] [CrossRef]
- Graves, D.B. The emerging role of reactive oxygen and nitrogen species in redox biology and some implications for plasma applications to medicine and biology. J. Phys. D Appl. Phys. 2012, 45, 263001. [Google Scholar] [CrossRef]
- Halliwell, B.; Gutteridge, J.M. Free Radicals In Biology and Medicine. J. Free Radic. Biol. Med. 2007, 1, 331–332. [Google Scholar] [CrossRef]
- Keidar, M.; Shashurin, A.; Volotskova, O.; Ann Stepp, M.; Srinivasan, P.; Sandler, A.; Trink, B. Cold atmospheric plasma in cancer therapy. Phys. Plasmas 2013, 20, 057101. [Google Scholar] [CrossRef]
- Keidar, M.; Walk, R.; Shashurin, A.; Srinivasan, P.; Sandler, A.; Dasgupta, S.; Ravi, R.; Guerrero-Preston, R.; Trink, B. Cold plasma selectivity and the possibility of a paradigm shift in cancer therapy. Br. J. Cancer 2011, 105, 1295–1301. [Google Scholar] [CrossRef]
- Ma, J.; Zhang, H.; Cheng, C.; Shen, J.; Bao, L.; Han, W. Contribution of hydrogen peroxide to non-thermal atmospheric pressure plasma induced A549 lung cancer cell damage. Plasma Process. Polym. 2017, 14, 1600162. [Google Scholar] [CrossRef]
- Kuo, S.P.; Tarasenko, O.; Chang, J.; Popovic, S.; Chen, C.Y.; Fan, H.W.; Scott, A.; Lahiani, M.; Alusta, P.; Drake, J.D. Contribution of a portable air plasma torch to rapid blood coagulation as a method of preventing bleeding. New J. Phys. 2009, 11, 115016. [Google Scholar] [CrossRef]
- Lee, J.; Kim, W.S.; Bae, K.B.; Yun, G.; Lee, J.K. Variation of Physical Parameters and Anomalous Healing Observation in Plasma Wound Healing. IEEE Trans. Plasma Sci. 2019, 47, 4833–4839. [Google Scholar] [CrossRef]
- Lloyd, G.; Friedman, G.; Jafri, S.; Schultz, G.; Fridman, A.; Harding, K. Gas Plasma: Medical Uses and Developments in Wound Care. Plasma Process. Polym. 2010, 7, 194–211. [Google Scholar] [CrossRef]
- Daeschlein, G.; von Woedtke, T.; Kindel, E.; Brandenburg, R.; Weltmann, K.D.; Jünger, M. Antibacterial Activity of an Atmospheric Pressure Plasma Jet Against Relevant Wound Pathogens in vitro on a Simulated Wound Environment. Plasma Process. Polym. 2010, 7, 224–230. [Google Scholar] [CrossRef]
- Heinlin, J.; Isbary, G.; Stolz, W.; Morfill, G.E.; Karrer, S. Plasma applications in medicine with a special focus on dermatology. J. Eur. Acad. Dermatol. Venereol. 2010, 25, 1–11. [Google Scholar] [CrossRef]
- Klämpfl, T.G.; Isbary, G.; Shimizu, T.; Li, Y.-F.; Zimmermann, J.L.; Stolz, W.; Schlegel, J.; Gregor, E.M.; Schmidt, H.-U. Cold Atmospheric Air Plasma Sterilization against Spores and Other Microorganisms of Clinical Interest. Appl. Environ. Microbiol. 2012, 78, 5077–5082. [Google Scholar] [CrossRef]
- Daeschlein, G.; Scholz, S.; von Woedtke, T.; Niggemeier, M.; Kindel, E.; Brandenburg, R.; Weltmann, K.-D.; Junger, M. In Vitro Killing of Clinical Fungal Strains by Low-Temperature Atmospheric-Pressure Plasma Jet. IEEE Trans. Plasma Sci. 2011, 39, 815–821. [Google Scholar] [CrossRef]
- He, Y.Y.; Ding, C.B.; Jin, T.; Fan, Y.Y.; Wu, Z.W.; Sun, M.W.; Wang, K.; Ji, T. Sensitivity of two drug-resistant bacteria to low-temperature air plasma in catheter-associated urinary tract infections under different environments. Plasma Sci. Technol. 2020, 22, 065502. [Google Scholar] [CrossRef]
- Bhatt, S.; Mehta, P.; Chen, C.; Daines, D.A.; Mermel, L.A.; Chen, H.L.; Kong, M.G. Antimicrobial Efficacy and Safety of a Novel Gas Plasma-Activated Catheter Lock Solution. Antimicrob. Agents Chemother. 2018, 62, e00744-18. [Google Scholar] [CrossRef]
- Laberge, A.; Arif, S.; Moulin, V.J. Microvesicles: Intercellular Messengers in Cutaneous Wound Healing. J. Cell. Physiol. 2018, 233, 5550–5563. [Google Scholar] [CrossRef]
- Sander, B.; Anke, S.; Lydia, B.; Kai, M.; Thomas, V.W.; Sybille, H.; Kristian, W. Redox Stimulation of Human THP-1 Monocytes in Response to Cold Physical Plasma. Oxidative Med. Cell. Longev. 2016, 2016, 5910695. [Google Scholar]
- Wende, K.; Strassenburg, S.; Haertel, B.; Harms, M.; Holtz, S.; Barton, A.; Masur, K.; Von Woedtke, T.; Lindequist, U. Atmospheric pressure plasma jet treatment evokes transient oxidative stress in HaCaT keratinocytes and influences cell physiology. Cell Biol. Int. 2014, 38, 412–425. [Google Scholar] [CrossRef] [PubMed]
- Schmidt, A.; Bekeschus, S.; Wende, K.; Vollmar, B.; Von Woedtke, T. A cold plasma jet accelerates wound healing in a murine model of full-thickness skin wounds. Exp. Dermatol. 2017, 26, 156–162. [Google Scholar] [CrossRef]
- Bekeschus, S.; Winterbourn, C.C.; Kolata, J.; Masur, K.; Hasse, S.; Broker, B.M.; Parker, H.A. Neutrophil extracellular trap formation is elicited in response to cold physical plasma. J. Leukoc. Biol. 2016, 100, 791–799. [Google Scholar] [CrossRef]
- Li, D.H.; Li, G.L.; Li, J.; Liu, Z.-Q.; Zhang, X.M.; Li, H.-P. Promotion of Wound Healing of Genetic Diabetic Mice Treated by a Cold Atmospheric Plasma Jet. IEEE Trans. Plasma Sci. 2019, 47, 4848–4860. [Google Scholar] [CrossRef]
- Kim, D.W.; Park, T.J.; Jang, S.J.; You, S.J.; Oh, W.Y. Plasma Treatment Effect on Angiogenesis in Wound Healing Process Evaluated in Vivo Using Angiographic Optical CoherenceTomography. Appl. Phys. Lett. 2016, 109, 233701. [Google Scholar] [CrossRef]
- Haertel, B.; Woedtke, T.V.; Weltmann, K.D.; Lindequist, U. Non-Thermal Atmospheric-Pressure Plasma Possible Application in Wound Healing. Biomol. Ther. 2014, 22, 477–490. [Google Scholar] [CrossRef] [PubMed]
- Li, Y.; Ho Kang, M.; Sup Uhm, H.; Lee, G.J.; Choi, E.H.; Han, I. Effects of atmospheric-pressure non-thermal bio-compatible plasma and plasma activated nitric oxide water on cervical cancer cells. Sci. Rep. 2017, 7, 45781. [Google Scholar] [CrossRef]
- Darny, T.; Pouvesle, J.-M.; Puech, V.; Douat, C.; Dozias, S.; Robert, E. Analysis of conductive target influence in plasma jet experiments through helium metastable and electric field measurements. Plasma Sources Sci. Technol. 2017, 26, 045008. [Google Scholar] [CrossRef]
- Szili, E.; Oh, J.-S.; Fukuhara, H.; Bhatia, R.; Gaur, N.; Nguyen, C.; Hong, S.-H.; Ito, S.; Ogawa, K.; Kawada, C. Modelling the helium plasma jet delivery of reactive species into a 3D cancer tumour. Plasma Sources Sci. Technol. 2018, 27, 014001. [Google Scholar] [CrossRef]
- Zhao, Y.; Chen, R.C.; Tian, E.Q.; Liu, D.P.; Niu, J.H.; Wang, W.C.; Qi, Z.H.; Xia, Y.; Song, Y.; Zhao, Z.G. Plasma-Activated Water Treatment of Fresh Beef: Bacterial Inactivation and Effects on Quality Attribute. IEEE Trans. Radiat. Plasma Med Sci. 2020, 4, 113–120. [Google Scholar] [CrossRef]
- Liu, K.; Yang, Z.H.; Liu, S.T. Study of the Characteristics of DC Multineedle-to-Water Plasma-Activated Water and Its Germination Inhibition Efficiency: The Effect of Discharge Mode and Gas Flow. IEEE Trans. Plasma Sci. 2020, 48, 969–979. [Google Scholar] [CrossRef]
- Wang, L.Y.; Xia, C.K.; Guo, Y.J.; Yang, C.J.; Cheng, C.; Zhao, J.; Yang, X.Y.; Cao, Z.C. Bactericidal efficacy of cold atmospheric plasma treatment against multidrug-resistant Pseudomonas aeruginosa. Future Microbiol. 2020, 15, 115–125. [Google Scholar] [CrossRef]
- Jones, L.M.; Dunham, D.; Rennie, M.Y.; Kirman, J.; Dacosta, R.S.; Lopez, A.J.; Keim, K.C.; Little, W.; Gomez, A.; Smith, A.C.; et al. In vitro detection of porphyrin-producing wound bacteria with real-time fluorescence imaging. Future Microbiol. 2020, 15, 319–332. [Google Scholar] [CrossRef]
- Traylor, M.J.; Pavlovich, M.J.; Karim, S.; Hait, P.; Graves, D.B. Long-term antibacterial efficacy of air plasma-activated water. J. Phys. D Appl. Phys. 2011, 44, 472001. [Google Scholar] [CrossRef]
- Zhou, R.; Zhou, R.; Prasad, K.; Fang, Z.; Speight, R.; Bazaka, K.; Ostrikov, K. Cold atmospheric plasma activated water as a prospective disinfectant: The crucial role of peroxynitrite. Green Chem. 2018, 20, 5276–5284. [Google Scholar] [CrossRef]
- Nakamura, K.; Peng, Y.; Utsumi, F.; Tanaka, H.; Mizuno, M.; Toyokuni, S.; Hori, M.; Kikkawa, F.; Kajiyama, H. Novel Intraperitoneal Treatment With Non-Thermal Plasma-Activated Medium Inhibits Metastatic Potential of Ovarian Cancer Cells. Sci. Rep. 2017, 7, 6085. [Google Scholar] [CrossRef] [PubMed]
- Liedtke, K.R.; Bekeschus, S.; Kaeding, A.; Hackbarth, C.; Kuehn, J.-P.; Heidecke, C.-D.; von Bernstorff, W.; von Woedtke, T.; Partecke, L.I. Non-thermal plasma-treated solution demonstrates antitumor activity against pancreatic cancer cells in vitro and in vivo. Sci. Rep. 2017, 7, 8319. [Google Scholar] [CrossRef] [PubMed]

| Indicator | Control | PAW |
|---|---|---|
| Albumin (g/L) | 27.21 ± 1.50 | 26.39 ± 0.96 |
| Aspartate aminotransferase (U/L) | 240.66 ± 48.69 | 245.03 ± 14.80 |
| Urea nitrogen (mg/dL) | 23.66 ± 1.70 | 22.82 ± 1.50 |
| Total cholesterol (mmol/L) | 3.84 ± 0.63 | 4.10 ± 0.51 |
| Glucose (mmol/L) | 7.74 ± 1.93 | 9.47 ± 0.93 |
| Potassium (mmol/L) | 11.18 ± 1.19 | 10.77 ± 1.01 |
| Total superoxide dismutase (U/mL) | 323.48 ± 50.91 | 310.34 ± 47.62 |
© 2020 by the authors. Licensee MDPI, Basel, Switzerland. This article is an open access article distributed under the terms and conditions of the Creative Commons Attribution (CC BY) license (http://creativecommons.org/licenses/by/4.0/).
Share and Cite
Xu, D.; Wang, S.; Li, B.; Qi, M.; Feng, R.; Li, Q.; Zhang, H.; Chen, H.; Kong, M.G. Effects of Plasma-Activated Water on Skin Wound Healing in Mice. Microorganisms 2020, 8, 1091. https://doi.org/10.3390/microorganisms8071091
Xu D, Wang S, Li B, Qi M, Feng R, Li Q, Zhang H, Chen H, Kong MG. Effects of Plasma-Activated Water on Skin Wound Healing in Mice. Microorganisms. 2020; 8(7):1091. https://doi.org/10.3390/microorganisms8071091
Chicago/Turabian StyleXu, Dehui, Shuai Wang, Bing Li, Miao Qi, Rui Feng, Qiaosong Li, Hao Zhang, Hailan Chen, and Michael G Kong. 2020. "Effects of Plasma-Activated Water on Skin Wound Healing in Mice" Microorganisms 8, no. 7: 1091. https://doi.org/10.3390/microorganisms8071091
APA StyleXu, D., Wang, S., Li, B., Qi, M., Feng, R., Li, Q., Zhang, H., Chen, H., & Kong, M. G. (2020). Effects of Plasma-Activated Water on Skin Wound Healing in Mice. Microorganisms, 8(7), 1091. https://doi.org/10.3390/microorganisms8071091

